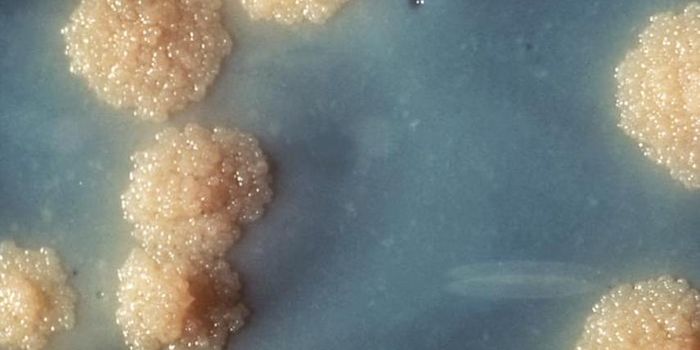
TB Vaccine Protects Two Times Longer Than Thought

Molecular Microbiology
Molecular Microbiology: The Division of Molecular Microbiology encompasses a spectrum of research that flows from fundamental science using model organisms to translational research on medically- and economically-significant species. The overarching purpose of the division is to further the science of molecular microbiology through innovative and internationally-recognized research on a broad platform of topics.
-
SEP 22, 2017CancerWith cancer putting up such strong fight, scientists are resorting to more unconventional therapies to give them the edg ...SEP 21, 2017Cell & Molecular BiologyOur immune system has to defend against many kinds of foreign invaders, like bacterial pathogens or viruses. But first, ...Written By: Carmen LeitchSEP 21, 2017CancerThe gut microbiome is increasingly recognized as a vital player in the development of colon cancer. But good bacteria, s ...SEP 17, 2017Cell & Molecular BiologyResearchers have found evidence that most tattoo inks contain tiny particles that can migrate away from the site of appl ...Written By: Carmen LeitchSEP 16, 2017Health & MedicineMost babies born with severe combined immune deficiency (SCID) don’t live past their first year of life, but there ...Written By: Kara MarkerSEP 15, 2017MicrobiologyA new type of enzyme has been discovered in hundreds of bacterial species, and researchers say it helps reveal how bacte ...Written By: Carmen LeitchSEP 14, 2017MicrobiologyOur bodies have an internal clock, the circadian rhythm, and it appears that some pathogens behave differently depending ...Written By: Carmen LeitchSEP 12, 2017Clinical & Molecular DXAdorable puppies could be behind a bacterial outbreak that has sickened 39 people across seven states so far. According ...SEP 11, 2017Clinical & Molecular DXAccording to the American College of Physicians and the Centers for Disease Control and Prevention (CDC), about 50 perce ...SEP 10, 2017MicrobiologyInflammation is a common feature of many diseases, and researchers wanted to know more about whether dormant bacteria ar ...Written By: Carmen LeitchSEP 07, 2017CardiologyA lot of things go wrong during sepsis, but one of the worst is heart complications. In the past researchers determined ...Written By: Kara MarkerSEP 05, 2017MicrobiologyNew work suggests that a TB vaccine might be doing more good than we knew, and should be used in areas with TB outbreaks ...Written By: Carmen LeitchSEP 04, 2017MicrobiologyResearchers have identified a gene involved in the complex relationship between our circadian rhythm, our metabolism, an ...Written By: Carmen LeitchSEP 03, 2017MicrobiologyI always jump at the chance to learn about a new microbe, and I’ve got a soft spot for protists - you know, the li ...Written By: Kerry EvansSEP 02, 2017Cell & Molecular BiologyScientists are following up on how a genetic region linked to autims impacts neuronal growth and appearance.Written By: Carmen LeitchSEP 01, 2017Cell & Molecular BiologyResearchers have solved a long-standing mystery about mitochondria.Written By: Carmen LeitchAUG 30, 2017Clinical & Molecular DXAfter waiting for months and even years for a kidney, those who had a successful kidney transplant must still continue t ...AUG 29, 2017MicrobiologyNew work by researchers at the University of Cambridge has provided insight into how tuberculosis infections get a footh ...Written By: Carmen LeitchAUG 29, 2017InfographicsOver the years, vaccines have prevented countless cases of disease and saved millions of lives. Currently, there are ove ...Written By: Liat Ben-SeniorAUG 28, 2017CancerThe US safety agency announced a more stringent oversight on stem-cell clinics to prevent the use of unapproved treatmen ...AUG 26, 2017Cell & Molecular BiologyResearchers created a phase diagram to describe how the components of a cell experience the cytoplasm in which they are ...Written By: Carmen LeitchAUG 23, 2017MicrobiologyScientists have discovered a mechanism used by microbes that live in salty lakes in Antarctica to aid growth and surviva ...Written By: Carmen LeitchAUG 23, 2017ImmunologyA bacterium called Staphylococcus aureus is arguably one of the world’s most dangerous superbugs. It made The Worl ...Written By: Kara MarkerAUG 22, 2017ImmunologyEver since penicillin was discovered in 1928, bacteria have been fighting back against every single antibiotic we develo ...Written By: Kara Marker
SEP 22, 2017
Cancer
With cancer putting up such strong fight, scientists are resorting to more unconventional therapies to give them the edg
...
SEP 21, 2017
Cell & Molecular Biology
Our immune system has to defend against many kinds of foreign invaders, like bacterial pathogens or viruses. But first,
...
Written By:
Carmen Leitch
SEP 21, 2017
Cancer
The gut microbiome is increasingly recognized as a vital player in the development of colon cancer. But good bacteria, s
...
SEP 17, 2017
Cell & Molecular Biology
Researchers have found evidence that most tattoo inks contain tiny particles that can migrate away from the site of appl
...
Written By:
Carmen Leitch
SEP 16, 2017
Health & Medicine
Most babies born with severe combined immune deficiency (SCID) don’t live past their first year of life, but there
...
Written By:
Kara Marker
SEP 15, 2017
Microbiology
A new type of enzyme has been discovered in hundreds of bacterial species, and researchers say it helps reveal how bacte
...
Written By:
Carmen Leitch
SEP 14, 2017
Microbiology
Our bodies have an internal clock, the circadian rhythm, and it appears that some pathogens behave differently depending
...
Written By:
Carmen Leitch
SEP 12, 2017
Clinical & Molecular DX
Adorable puppies could be behind a bacterial outbreak that has sickened 39 people across seven states so far. According
...
SEP 11, 2017
Clinical & Molecular DX
According to the American College of Physicians and the Centers for Disease Control and Prevention (CDC), about 50 perce
...
SEP 10, 2017
Microbiology
Inflammation is a common feature of many diseases, and researchers wanted to know more about whether dormant bacteria ar
...
Written By:
Carmen Leitch
SEP 07, 2017
Cardiology
A lot of things go wrong during sepsis, but one of the worst is heart complications. In the past researchers determined
...
Written By:
Kara Marker
SEP 05, 2017
Microbiology
New work suggests that a TB vaccine might be doing more good than we knew, and should be used in areas with TB outbreaks
...
Written By:
Carmen Leitch
SEP 04, 2017
Microbiology
Researchers have identified a gene involved in the complex relationship between our circadian rhythm, our metabolism, an
...
Written By:
Carmen Leitch
SEP 03, 2017
Microbiology
I always jump at the chance to learn about a new microbe, and I’ve got a soft spot for protists - you know, the li
...
Written By:
Kerry Evans
SEP 02, 2017
Cell & Molecular Biology
Scientists are following up on how a genetic region linked to autims impacts neuronal growth and appearance.
Written By:
Carmen Leitch
SEP 01, 2017
Cell & Molecular Biology
Researchers have solved a long-standing mystery about mitochondria.
Written By:
Carmen Leitch
AUG 30, 2017
Clinical & Molecular DX
After waiting for months and even years for a kidney, those who had a successful kidney transplant must still continue t
...
AUG 29, 2017
Microbiology
New work by researchers at the University of Cambridge has provided insight into how tuberculosis infections get a footh
...
Written By:
Carmen Leitch
AUG 29, 2017
Infographics
Over the years, vaccines have prevented countless cases of disease and saved millions of lives. Currently, there are ove
...
Written By:
Liat Ben-Senior
AUG 28, 2017
Cancer
The US safety agency announced a more stringent oversight on stem-cell clinics to prevent the use of unapproved treatmen
...
AUG 26, 2017
Cell & Molecular Biology
Researchers created a phase diagram to describe how the components of a cell experience the cytoplasm in which they are
...
Written By:
Carmen Leitch
AUG 23, 2017
Microbiology
Scientists have discovered a mechanism used by microbes that live in salty lakes in Antarctica to aid growth and surviva
...
Written By:
Carmen Leitch
AUG 23, 2017
Immunology
A bacterium called Staphylococcus aureus is arguably one of the world’s most dangerous superbugs. It made The Worl
...
Written By:
Kara Marker
AUG 22, 2017
Immunology
Ever since penicillin was discovered in 1928, bacteria have been fighting back against every single antibiotic we develo
...
Written By:
Kara Marker